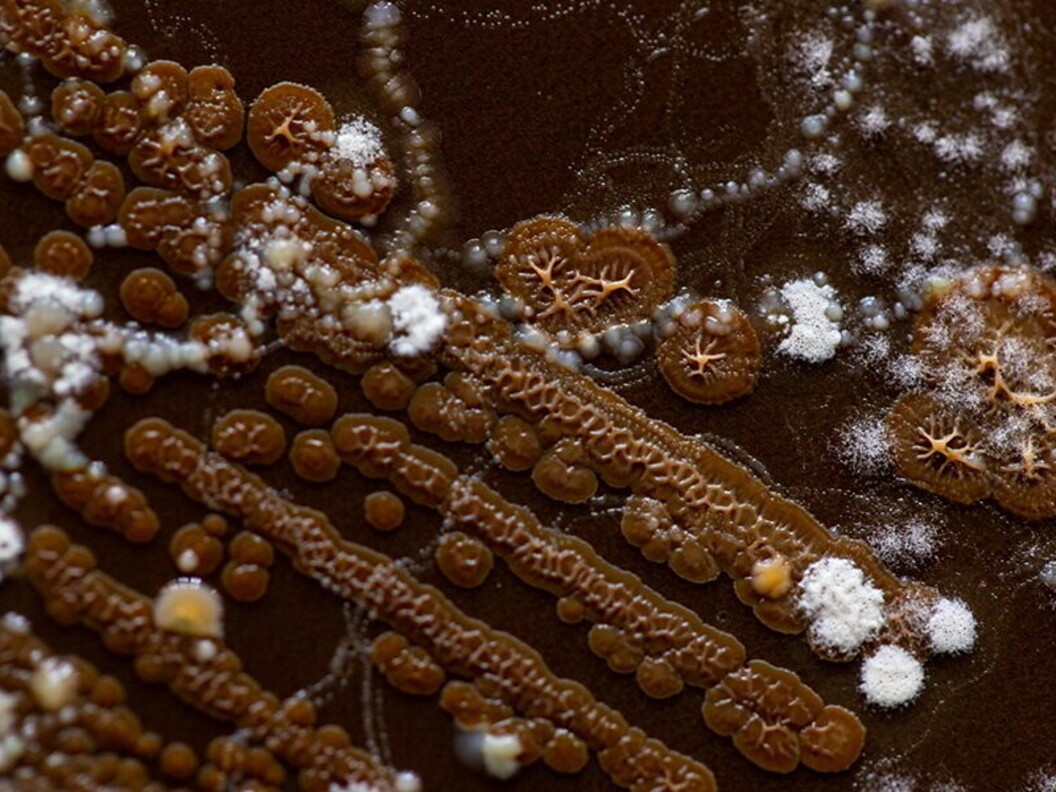
Batteri e funghi

Talpa
Siamo abituati a pensare al suolo, alla terra, come a un materiale solido inerte, privo di vita, costituito da particelle minerali di diversa grandezza (ghiaia, sabbia, limo, argilla) e da una piccola parte di materiale organico. In realtà, grazie all’aria e all’acqua che circolano negli spazi vuoti (pori) presenti tra le diverse particelle, e grazie alle sostanze in esso presenti, il suolo rappresenta un ambiente favorevole allo sviluppo della vita. Batteri, funghi, piante e animali (in vertebrati e piccoli vertebrati) trovano nel terreno tutto ciò di cui hanno bisogno per sopravvivere e riprodursi, interagendo tra loro e con il suolo nella continua e ciclica trasformazione della materia inorganica in materia organica e viceversa..